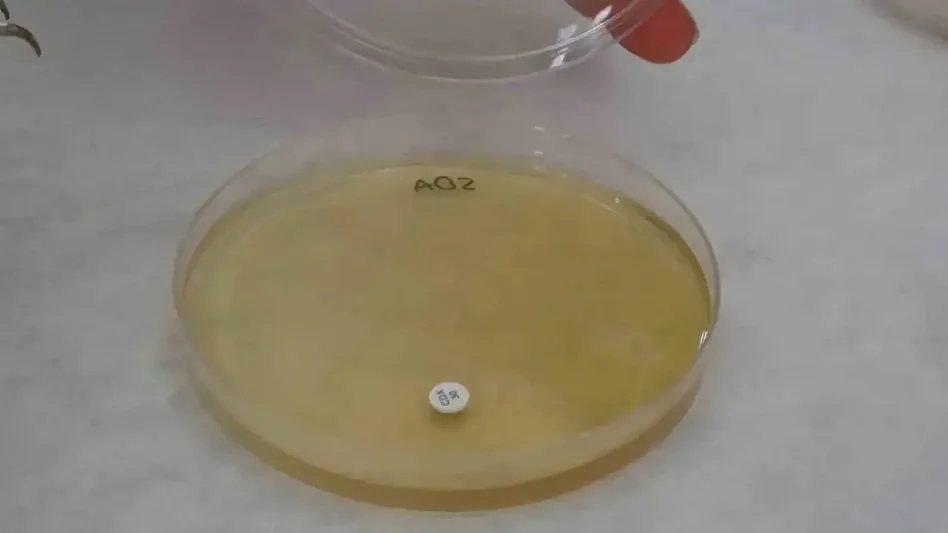

Malatya’da ortaya çıktı: Bilimsel olarak doğrulandı etkisi yüzde 90’a dayandı… Ticari değeri hızla yükseliyor
Malatya’da yetişen endemik Hypericum malatyanum (Malatya kantaronu) üzerine yapılan bilimsel araştırmada, bitkinin yaygın olarak bilinen Hypericum perforatum (sarı kantaron) türüne göre içerik bakımından kimyasal zenginliği fazla çıktı.

Malatya Turgut Özal Üniversitesi’nden Prof. Dr. Şanlı Kabaktepe, Dr. Öğr. Üyesi Elif Özbey ve İnönü Üniversitesi’nden Prof. Dr. Dilek Asma tarafından ortak yürütülen çalışmada, Malatya florasında yetişen Hypericum malatyanum (Malatya kantaronu) ve Hypericum perforatum (sarı kantaron) kimyasal bileşimleri ile biyolojik aktiviteleri karşılaştırıldı. Bitkiler bölgeden toplanarak Malatya Turgut Özal Üniversitesi laboratuvarlarında analiz edildi.

Araştırma ekibinden Dr. Öğr. Üyesi Elif Özbey ise Malatya kantaronunun ekolojik şartlarına özgü zengin fitokimyasal içeriğinin altını çizdi. Özbey, özellikle antioksidan aktivitenin dikkat çekici olduğunu belirterek, “Endemik türün antioksidan aktivitesinin konsantrasyona bağlı olarak yüzde 90’a varan radikal süpürücü etki gösterdiğini tespit ettik. Bu, oksidatif stresle mücadelede önemli bir doğal kaynak olduğunu ortaya koyuyor” dedi.

Antimikrobiyal testlerde de iki bitkinin farklı mikroorganizmalara karşı değişen düzeylerde etki gösterdiği belirlendi. Özbey, “Her iki tür aynı cinse ait olsa da farklı kimyasal profillere sahip olmaları nedeniyle terapötik potansiyelleri de farklılık gösteriyor” ifadelerini kullandı.
Araştırmada her iki türe ait yaklaşık 30 kimyasal bileşen analiz edildiğini kaydeden Dr. Öğr. Üyesi Elif Özbey, “Bu bileşenlerin önemli bir bölümünde türler arasında çeşit ve miktar farklılıkları bulundu. Hiperisin, hiperforin, uçucu yağlar, fenolik bileşikler ve yağ asitlerinin türler arası farklı oranlarda bulundu” dedi.

Özbey, Malatya kantaronunun zengin kimyasal yapısı sayesinde ilaç sanayisi, gıda ve kozmetik sektörlerinde potansiyel kullanım alanlarının bulunduğunu da ifade etti. Araştırma ekibi endemik bitkilerin korunmasının ve bilimsel yönlerinin ortaya çıkarılmasının önemine de dikkat çekerek çalışmanın Malatya kantaronunun bilimsel açıdan ilk kez bu kapsamda değerlendirilmiş olması nedeniyle özgün bir nitelik taşıdığını belirtti.